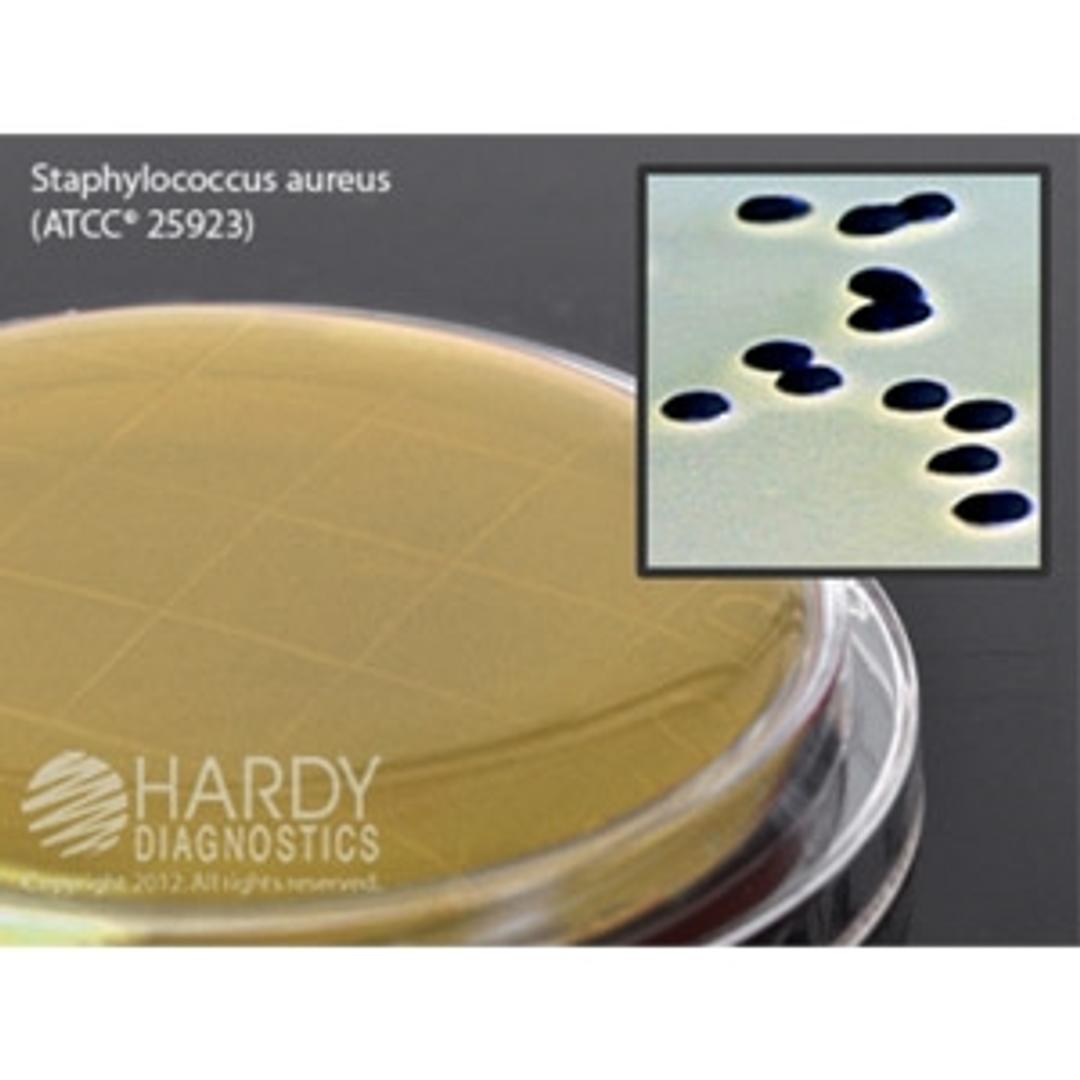
Baird-Parker Agar - Hardy Diagnostics - Life Sciences

Baird-Parker Agar
Baird-Parker Agar, for Staphylococcus, contact plate with Lok-Tight™ friction lid, optional locking feature.
The supplier does not provide quotations for this product through SelectScience. You can search for similar products in our Product Directory.
Great value for the money
Agar for staph testing
It is half the price than other suppliers, still great quality, easy to use, packaged nicely.
Review Date: 22 Oct 2021 | Hardy Diagnostics
- Friction lid
The friction lid design keeps lids in place before sampling.
- Lok-Tight™ Locking Lid
An optional locking feature means lids stay secured post sampling and during transport to your lab.
- Molded Grid
Each plate has a grid molded into the bottom of the plate to aid in the counting of microorganisms.
- Certificate of Analysis
Available online for each lot.